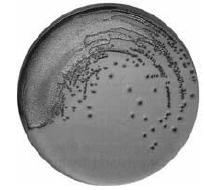
Enunciado 3301209-1

Foram encontradas 120 questões.
Disciplina: Serviços Gerais
Banca: CESPE / CEBRASPE
Orgão: Pref. Vitória-ES
Os testes hematológicos servem a uma ampla gama de investigações clínicas, podendo ser aplicados a diagnóstico de anemias, distúrbios de coagulação, processos infecciosos ou mesmo a problemas relacionados à transfusão de sangue. Acerca de tais testes, julgue os itens que se seguem.
A eosinofilia é determinada por meio de provas de coagulação.
Provas
Disciplina: Serviços Gerais
Banca: CESPE / CEBRASPE
Orgão: Pref. Vitória-ES
Os testes hematológicos servem a uma ampla gama de investigações clínicas, podendo ser aplicados a diagnóstico de anemias, distúrbios de coagulação, processos infecciosos ou mesmo a problemas relacionados à transfusão de sangue. Acerca de tais testes, julgue os itens que se seguem.
O tempo de agregação plaquetária pode ser medido por microscopia, caso não seja possível usar um agregômetro.
Provas
Disciplina: Serviços Gerais
Banca: CESPE / CEBRASPE
Orgão: Pref. Vitória-ES
Os testes hematológicos servem a uma ampla gama de investigações clínicas, podendo ser aplicados a diagnóstico de anemias, distúrbios de coagulação, processos infecciosos ou mesmo a problemas relacionados à transfusão de sangue. Acerca de tais testes, julgue os itens que se seguem.
A prova de fragilidade capilar deve ser feita colhendo-se o sangue do paciente em tubo com citrato.
Provas
Disciplina: Serviços Gerais
Banca: CESPE / CEBRASPE
Orgão: Pref. Vitória-ES
Os testes hematológicos servem a uma ampla gama de investigações clínicas, podendo ser aplicados a diagnóstico de anemias, distúrbios de coagulação, processos infecciosos ou mesmo a problemas relacionados à transfusão de sangue. Acerca de tais testes, julgue os itens que se seguem.
Os valores de volume corpuscular médio e hemoglobina corpuscular média podem ser calculados a partir da dosagem de hemoglobina, da medida do hematócrito e da contagem de eritrócitos.
Provas
Disciplina: Serviços Gerais
Banca: CESPE / CEBRASPE
Orgão: Pref. Vitória-ES
Os testes hematológicos servem a uma ampla gama de investigações clínicas, podendo ser aplicados a diagnóstico de anemias, distúrbios de coagulação, processos infecciosos ou mesmo a problemas relacionados à transfusão de sangue. Acerca de tais testes, julgue os itens que se seguem.
A prova de Coombs indireta é usada para se demonstrar a presença de anticorpos no soro do paciente.
Provas
Disciplina: Serviços Gerais
Banca: CESPE / CEBRASPE
Orgão: Pref. Vitória-ES
Os testes hematológicos servem a uma ampla gama de investigações clínicas, podendo ser aplicados a diagnóstico de anemias, distúrbios de coagulação, processos infecciosos ou mesmo a problemas relacionados à transfusão de sangue. Acerca de tais testes, julgue os itens que se seguem.
O teste de aglutinação direta é usado na tipagem sanguínea ABO.
Provas
Disciplina: Serviços Gerais
Banca: CESPE / CEBRASPE
Orgão: Pref. Vitória-ES

A microbiologia clínica está-se tornando mais complexa devido a diversos fatores, tais como a maior sobrevida de pacientes, o uso de corticosteróides em doses elevadas, o uso de drogas antitumorais e o uso indiscriminado de antibióticos. Por um lado, observa-se um maior número de pacientes debilitados, que apresentam maior suscetibilidade às infecções, seja devido a doenças ou a tratamentos que levam à imunossupressão. Por outro lado, o mau uso de agentes antimicrobianos leva à seleção de organismos resistentes e de difícil tratamento. Nesse contexto, a atuação do laboratório de microbiologia clínica é fundamental, desde o preparo para a coleta de material até a informação do resultado. Considerando os aspectos da microbiologia e a figura acima, que mostra um resultado comum em laboratórios de microbiologia, julgue os itens subseqüentes.
A cultura em meio McConkey é um método adequado para a realização de coprocultura.
Provas
Disciplina: Serviços Gerais
Banca: CESPE / CEBRASPE
Orgão: Pref. Vitória-ES

A microbiologia clínica está-se tornando mais complexa devido a diversos fatores, tais como a maior sobrevida de pacientes, o uso de corticosteróides em doses elevadas, o uso de drogas antitumorais e o uso indiscriminado de antibióticos. Por um lado, observa-se um maior número de pacientes debilitados, que apresentam maior suscetibilidade às infecções, seja devido a doenças ou a tratamentos que levam à imunossupressão. Por outro lado, o mau uso de agentes antimicrobianos leva à seleção de organismos resistentes e de difícil tratamento. Nesse contexto, a atuação do laboratório de microbiologia clínica é fundamental, desde o preparo para a coleta de material até a informação do resultado. Considerando os aspectos da microbiologia e a figura acima, que mostra um resultado comum em laboratórios de microbiologia, julgue os itens subseqüentes.
O diagnóstico de infecção por T. cruzi é feito por coloração de esfregaço de escarro pelo método de Ziehl-Neelsen.
Provas
Disciplina: Serviços Gerais
Banca: CESPE / CEBRASPE
Orgão: Pref. Vitória-ES

A microbiologia clínica está-se tornando mais complexa devido a diversos fatores, tais como a maior sobrevida de pacientes, o uso de corticosteróides em doses elevadas, o uso de drogas antitumorais e o uso indiscriminado de antibióticos. Por um lado, observa-se um maior número de pacientes debilitados, que apresentam maior suscetibilidade às infecções, seja devido a doenças ou a tratamentos que levam à imunossupressão. Por outro lado, o mau uso de agentes antimicrobianos leva à seleção de organismos resistentes e de difícil tratamento. Nesse contexto, a atuação do laboratório de microbiologia clínica é fundamental, desde o preparo para a coleta de material até a informação do resultado. Considerando os aspectos da microbiologia e a figura acima, que mostra um resultado comum em laboratórios de microbiologia, julgue os itens subseqüentes.
Durante uma bacterioscopia, o aquecimento da amostra não deve ser realizado, independentemente da coloração utilizada, uma vez que esse procedimento degradaria os microrganismos.
Provas
Disciplina: Serviços Gerais
Banca: CESPE / CEBRASPE
Orgão: Pref. Vitória-ES
A microbiologia clínica está-se tornando mais complexa devido a diversos fatores, tais como a maior sobrevida de pacientes, o uso de corticosteróides em doses elevadas, o uso de drogas antitumorais e o uso indiscriminado de antibióticos. Por um lado, observa-se um maior número de pacientes debilitados, que apresentam maior suscetibilidade às infecções, seja devido a doenças ou a tratamentos que levam à imunossupressão. Por outro lado, o mau uso de agentes antimicrobianos leva à seleção de organismos resistentes e de difícil tratamento. Nesse contexto, a atuação do laboratório de microbiologia clínica é fundamental, desde o preparo para a coleta de material até a informação do resultado. Considerando os aspectos da microbiologia e a figura acima, que mostra um resultado comum em laboratórios de microbiologia, julgue os itens subseqüentes.
O tratamento com detergentes e hipoclorito de sódio a 0,2% (v/v) é suficiente para a esterilização do material utilizado em coproculturas.
Provas
Caderno Container